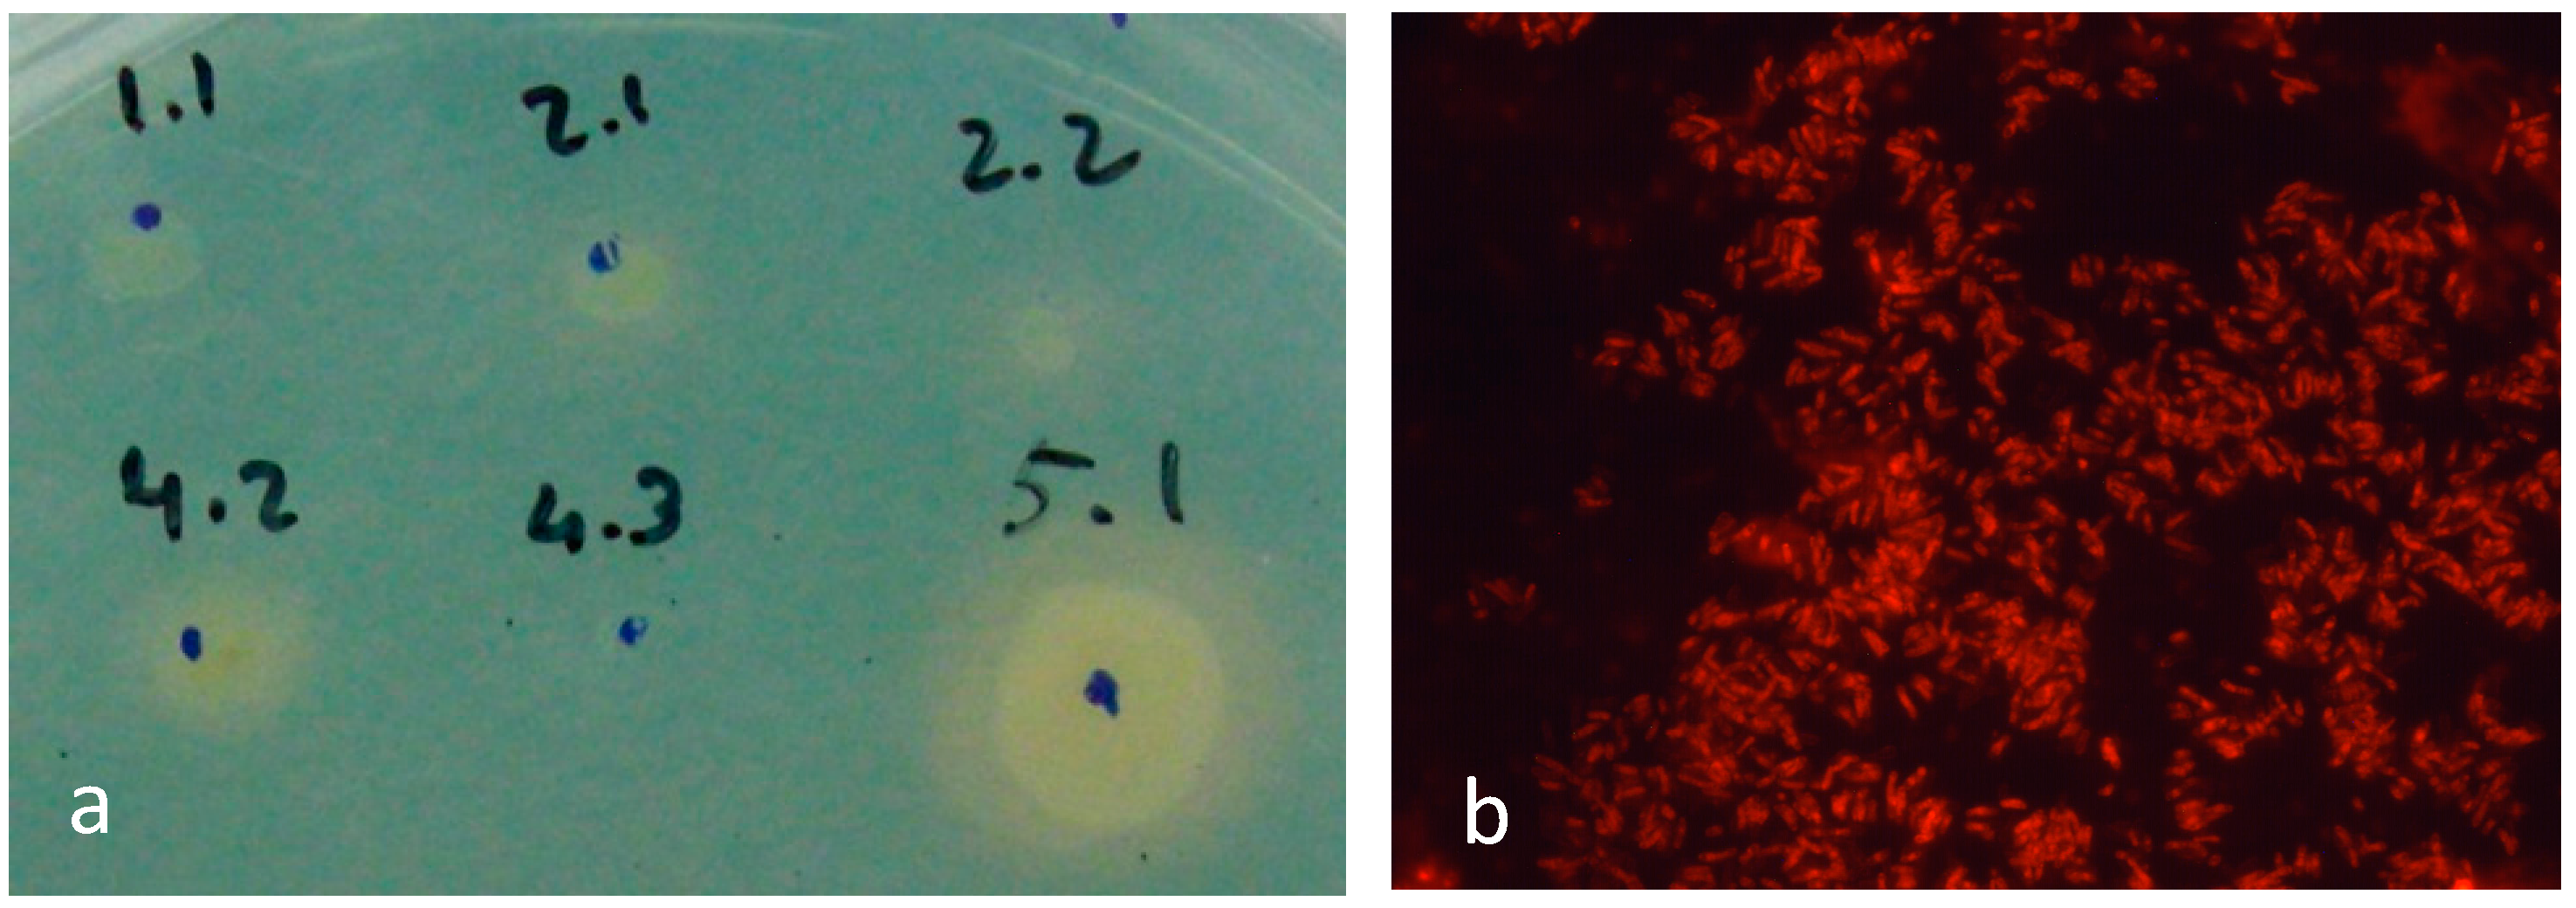
Materials 10 00788 g001

Using Biotechnology to Solve Engineering Problems: Non-Destructive Testing of Microfabrication Components
Abstract
:1. Introduction
2. Results
2.1. Identifying Suitable Bacteria for NDT
2.2. Influencing Bacterial Properties to Help Cell Adhesion
2.3. Application of Magnetic and Electric Fields to Help Bacterial Distribution
2.4. Application of Bacterial Cells for the Identification of Standard Defects
- selection of the area to inspect;
- surface cleaning;
- deposition of bacterial suspension;
- penetration by and adherence of bacteria to defects;
- removal of the excess of bacterial suspension;
- inspection and evaluation of the surface using a microscope with fluorescent light;
- cleaning and sterilization of the material.
2.5. Application of Bacterial Cells for the Identification of Real Defects
3. Discussion
4. Materials and Methods
4.1. Strains and Bacterial Growth
4.2. Zeta Potential
4.3. Detection of Siderophores
4.4. Surface Tension of Culture Supernatants
4.5. Application of Magnetic Fields under the Microscope
4.6. Application of Electric Fields under the Microscope
Acknowledgments
Author Contributions
Conflicts of Interest
References
- Meng, J.; Loh, N.H.; Fu, G.; Tor, S.B.; Tay, B.Y. Replication and characterization of 316L stainless steel micro-mixer by micro powder injection molding. J. Alloys Compd. 2010, 496, 293–299. [Google Scholar] [CrossRef]
- Ghoni, R.; Dollah, M.; Sulaiman, A.; Ibrahim, F.M. Defect characterization based on eddy current technique: Technical review. Adv. Mech. Eng. 2014, 6, 182496. [Google Scholar] [CrossRef]
- Cherry, M.R.; Sathish, S.; Welter, J.; Reibel, R.; Blodgett, M.P. Development of high resolution eddy current imaging using an electro-mechanical sensor. AIP Conf. Proc. 2012, 1430, 324–331. [Google Scholar]
- Abdelhamid, M.; Singh, R.; Omar, M. Review of microcrack detection techniques for silicon solar cells. IEEE J. Photovolt. 2014, 4, 514–524. [Google Scholar] [CrossRef]
- Ibrahim, M.E. Nondestructive evaluation of thick-section composites and sandwich structures: A review. Compos. Part A 2014, 64, 36–48. [Google Scholar] [CrossRef]
- Jolly, M.R.; Prabhakar, A.; Sturzu, B.; Hollstein, K.; Singh, R.; Thomas, S.; Foote, P.; Shaw, A. Review of non-destructive testing (NDT) techniques and their applicability to thick walled composites. Procedica CIRP 2015, 38, 129–136. [Google Scholar] [CrossRef]
- McMaster, R.C. Liquid Penetrant Tests. In Nondestructive Testing Handbook, 3rd ed.; American Society for Nondestructive Testing: Columbus, OH, USA; Volume 2, 1982; p. 616. [Google Scholar]
- Eisenmann, D.J.; Enyart, D.; Lo, C.; Brasche, L. Review of progress in magnetic particle inspection. AIP Conf. Proc. 2014, 1581, 1505–1510. [Google Scholar]
- KTN. A Landscape for the Future of NDT in the UK Economy; Materials KTN: London, UK, 2014. [Google Scholar]
- Hsu, J.W.P. Near-field scanning optical microscopy studies of electronic and photonic materials and devices. Mater. Sci. Eng. R Rep. 2001, 33, 1–50. [Google Scholar] [CrossRef]
- Santos, T.G.; Miranda, R.M.; de Carvalho, C.C.C.R. A new NDT technique based on bacterial cells to detect micro surface defects. NDT E Int. 2014, 63, 43–49. [Google Scholar] [CrossRef]
- Santos, T.G.; Miranda, R.M.; Vieira, M.T.; Farinha, A.R.; Ferreira, T.J.; Quintino, L.; Vilaça, P.; de Carvalho, C.C.C.R. Developments in micro- and nano-defects detection using bacterial cells. NDT E Int. 2016, 78, 20–28. [Google Scholar] [CrossRef]
- García-Martín, J.; Gómez-Gil, J.; Vázquez-Sánchez, E. Non-destructive techniques based on eddy current testing. Sensors 2011, 11, 2525–2565. [Google Scholar] [CrossRef] [PubMed]
- Van Oss, C.J. Hydrophobicity of biosurfaces—Origin, quantitative determination and interaction energies. Colloids Surf. B Biointerfaces 1995, 5, 91–110. [Google Scholar] [CrossRef]
- Boks, N.P.; Norde, W.; van der Mei, H.C.; Busscher, H.J. Forces involved in bacterial adhesion to hydrophilic and hydrophobic surfaces. Microbiology 2008, 154, 3122–3133. [Google Scholar] [CrossRef] [PubMed]
- Al-Abdalall, A.H.A. Isolation and identification of microbes associated with mobile phones in Dammam in eastern Saudi Arabia. J. Fam. Community Med. 2010, 17, 11–14. [Google Scholar] [CrossRef] [PubMed]
- Gashaw, M.; Abtew, D.; Addis, Z. Prevalence and antimicrobial susceptibility pattern of bacteria isolated from mobile phones of health care professionals working in Gondar town health centers. ISRN Public Health 2014, 2014. [Google Scholar] [CrossRef]
- Beasley, F.C.; Heinrichs, D.E. Siderophore-mediated iron acquisition in the staphylococci. J. Inorg. Biochem. 2010, 104, 282–288. [Google Scholar] [CrossRef] [PubMed]
- De Carvalho, C.C.C.R.; Marques, M.P.C.; Fernandes, P. Recent achievements on siderophore production and application. Recent Pat. Biotechnol. 2011, 5, 183–198. [Google Scholar] [CrossRef] [PubMed]
- Brown, J.S.; Holden, D.W. Iron acquisition by gram-positive bacterial pathogens. Microb. Infect. 2002, 4, 1149–1156. [Google Scholar] [CrossRef]
- Schmaler, M.; Jann, N.J.; Ferracin, F.; Landolt, L.Z.; Biswas, L.; Götz, F.; Landmann, R. Lipoproteins in Staphylococcus aureus mediate inflammation by TLR2 and iron-dependent growth in vivo. J. Immunol. 2009, 182, 7110–7118. [Google Scholar] [CrossRef] [PubMed]
- Vainshtein, M.; Suzina, N.; Kudryashova, E.; Ariskina, E. New magnet-sensitive structures in bacterial and archaeal cells. Biol. Cell 2002, 94, 29–35. [Google Scholar] [CrossRef]
- De Carvalho, C.C.C.R.; Wick, L.; Heipieper, H. Cell wall adaptations of planktonic and biofilm Rhodococcus erythropolis cells to growth on C5 to C16 n-alkane hydrocarbons. Appl. Microbiol. Biotechnol. 2009, 82, 311–320. [Google Scholar] [CrossRef] [PubMed]
- De Carvalho, C.C.C.R.; da Fonseca, M.M.R. Preventing biofilm formation: Promoting cell separation with terpenes. FEMS Microbiol. Ecol. 2007, 61, 406–413. [Google Scholar] [CrossRef] [PubMed]
- Rodrigues, C.J.C.; de Carvalho, C.C.C.R. Rhodococcus erythropolis cells adapt their fatty acid composition during biofilm formation on metallic and non-metallic surfaces. FEMS Microbiol. Ecol. 2015, 91. [Google Scholar] [CrossRef] [PubMed]
- Hermansson, M. The DLVO theory in microbial adhesion. Colloids Surf. B Biointerfaces 1999, 14, 105–119. [Google Scholar] [CrossRef]
- De Carvalho, C.C.C.R.; Caramujo, M.J. Ancient procedures for the high-tech world: Health benefits and antimicrobial compounds from the Mediterranean empires. Open Biotechnol. J. 2008, 2, 235–246. [Google Scholar] [CrossRef]
- Villapún, V.; Dover, L.; Cross, A.; González, S. Antibacterial metallic touch surfaces. Materials 2016, 9, 736. [Google Scholar] [CrossRef]
- De Carvalho, C.C.C.R. Biofilms: New ideas for an old problem. Recent Pat. Biotechnol. 2012, 6, 13–22. [Google Scholar] [CrossRef] [PubMed]
- Girardello, R.; Bispo, P.J.M.; Yamanaka, T.M.; Gales, A.C. Cation concentration variability of four distinct Mueller-Hinton agar brands influences polymyxin b susceptibility results. J. Clin. Microbiol. 2012, 50, 2414–2418. [Google Scholar] [CrossRef] [PubMed]
- Morrissey, J.A.; Cockayne, A.; Brummell, K.; Williams, P. The staphylococcal ferritins are differentially regulated in response to iron and manganese and via PerR and Fur. Infect. Immun. 2004, 72, 972–979. [Google Scholar] [CrossRef] [PubMed]
- Frankel, R.B.; Blakemore, R.P.; Wolfe, R.S. Magnetite in freshwater magnetotactic bacteria. Science 1979, 203, 1355–1356. [Google Scholar] [CrossRef] [PubMed]
- Pereira, A.S.; Timóteo, C.G.; Guilherme, M.; Folgosa, F.; Naik, S.G.; Duarte, A.G.; Huynh, B.H.; Tavares, P. Spectroscopic evidence for and characterization of a trinuclear ferroxidase center in bacterial ferritin from Desulfovibrio vulgaris hildenborough. J. Am. Chem. Soc. 2012, 134, 10822–10832. [Google Scholar] [CrossRef] [PubMed]
- Owen, C.S.; Lindsay, J.G. Ferritin as a label for high-gradient magnetic separation. Biophys. J. 1983, 42, 145–150. [Google Scholar] [CrossRef]
- Tuḡrul, A.B. Capillarity effect analysis for alternative liquid penetrant chemicals. NDT E Int. 1997, 30, 19–23. [Google Scholar] [CrossRef]
- Sapienza, R.S.; Ricks, W.F.; Grunden, B.L.; Heater, K.J.; Badowski, D.E.; Sanders, J.W. Environmentally Acceptable Alternatives for Non-Destructive Inspection with Fluorescent Penetrant Dyes; METSS Corporation: Arlington, TX, USA, 2003. [Google Scholar]
- Sheng, X.; Ting, Y.P.; Pehkonen, S.O. Force measurements of bacterial adhesion on metals using a cell probe atomic force microscope. J. Colloid Interface Sci. 2007, 310, 661–669. [Google Scholar] [CrossRef] [PubMed]
- Kunitsky, C.; Osterhout, G.; Sasser, M. Identification of microorganisms using fatty acid methyl ester (fame) analysis and the midi sherlock microbial identification system. In Encyclopedia of Rapid Microbiological Methods; Miller, M.J., Ed.; Davis Healthcare International Publishing, LLC: Baltimore, MD, USA, 2005; Volume 3, pp. 1–17. [Google Scholar]
- de Carvalho, C.C.C.R.; Caramujo, M.J. Bacterial diversity assessed by cultivation-based techniques shows predominance of Staphylococccus species on coins collected in Lisbon and Casablanca. FEMS Microbiol. Ecol. 2014, 88, 26–37. [Google Scholar] [CrossRef] [PubMed]
- Nadais, H.; Barbosa, M.; Capela, I.; Arroja, L.; Ramos, C.G.; Grilo, A.; Sousa, S.A.; Leitão, J.H. Enhancing wastewater degradation and biogas production by intermittent operation of UASB reactors. Energy 2011, 36, 2164–2168. [Google Scholar] [CrossRef]
- Rudi, K.; Skulberg, O.M.; Larsen, F.; Jakobsen, K.S. Strain characterization and classification of oxyphotobacteria in clone cultures on the basis of 16s rRNA sequences from the variable regions v6, v7, and v8. Appl. Environ. Microbiol. 1997, 63, 2593–2599. [Google Scholar] [PubMed]
- Johnson, M.; Zaretskaya, I.; Raytselis, Y.; Merezhuk, Y.; McGinnis, S.; Madden, T.L. Ncbi blast: A better web interface. Nucl. Acids Res. 2008, 36, W5–W9. [Google Scholar] [CrossRef] [PubMed]
- Van der Werf, M.J.; Swarts, H.J.; de Bont, J.A.M. Rhodococcus erythropolis DCL14 contains a novel degradation pathway for limonene. Appl. Environ. Microbiol. 1999, 65, 2092–2102. [Google Scholar] [PubMed]
- Cortes, M.A.L.R.M.; de Carvalho, C.C.C.R. Effect of carbon sources on lipid accumulation in Rhodococcus cells. Biochem. Eng. J. 2015, 94, 100–105. [Google Scholar] [CrossRef]
- Hiemenz, P.C.; Rajagopalan, R. Principles of Colloid and Surface Chemistry, 3rd ed.; Marcel Dekker Inc.: New York, NY, USA, 1997; p. 672. [Google Scholar]
- Schwyn, B.; Neilands, J.B. Universal chemical assay for the detection and determination of siderophores. Anal. Biochem. 1987, 160, 47–56. [Google Scholar] [CrossRef]
- Adamson, A.W. Physical Chemistry of Surfaces; John Wiley & Sons Inc.: New York, NY, USA, 1990; p. 777. [Google Scholar]

© 2017 by the authors. Licensee MDPI, Basel, Switzerland. This article is an open access article distributed under the terms and conditions of the Creative Commons Attribution (CC BY) license (http://creativecommons.org/licenses/by/4.0/).
Share and Cite
De Carvalho, C.C.C.R.; Inácio, P.L.; Miranda, R.M.; Santos, T.G. Using Biotechnology to Solve Engineering Problems: Non-Destructive Testing of Microfabrication Components. Materials 2017, 10, 788. https://doi.org/10.3390/ma10070788
De Carvalho CCCR, Inácio PL, Miranda RM, Santos TG. Using Biotechnology to Solve Engineering Problems: Non-Destructive Testing of Microfabrication Components. Materials. 2017; 10(7):788. https://doi.org/10.3390/ma10070788
Chicago/Turabian StyleDe Carvalho, Carla C. C. R., Patrick L. Inácio, Rosa M. Miranda, and Telmo G. Santos. 2017. "Using Biotechnology to Solve Engineering Problems: Non-Destructive Testing of Microfabrication Components" Materials 10, no. 7: 788. https://doi.org/10.3390/ma10070788
APA StyleDe Carvalho, C. C. C. R., Inácio, P. L., Miranda, R. M., & Santos, T. G. (2017). Using Biotechnology to Solve Engineering Problems: Non-Destructive Testing of Microfabrication Components. Materials, 10(7), 788. https://doi.org/10.3390/ma10070788

